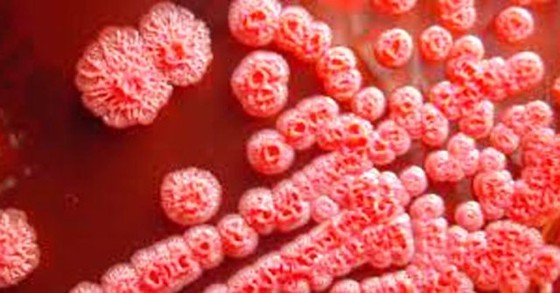
Disease controller confirms two deaths caused by Whitmore’s Disease in Hanoi

The rare cases should be noticeable because they are siblings living in the same house.
Presently, the center is working with the National Institute of Hygiene and Epidemiology and related institutions to investigate all epidemiologic factors and carry out researches as well as keep track on the disease development to have timely warning to residents, said Dr. Cam.
According to Deputy Director of the National Children Hospital Dr. Tran Minh Dien, two children killed by the disease are a five year old boy and a 1.5 year old boy in Do Luong village. The five year old boy was admitted to the Hanoi-based Vietnam National Children’s Hospital on October 28 and diagnosed to have septic shock. The boy died after three days.
Ten days later, his younger brother also experienced fever. He was soon rushed to the hospital but he died on November 16.
Two children tested positive for Whitmore's Disease.
Noticeably, the family’s eldest child had previously been killed but not because of Whitmore’s Disease. The family has 7 members but their parents and grandfather are still healthy.
According to medical workers, also known as melioidosis, Whitmore's Disease is an infectious disease that can infect humans or animals. The disease is caused by the bacterium Burkholderia pseudomallei, which can be found in contaminated water and soil and is often spread to humans through direct contact, such as open wounds, with the contamination source.
Currently, there is no vaccine available for the disease.
In order to prevent Whitmore's Disease, it is recommended that people wear protective clothing and gear when contacting water and soil.
























